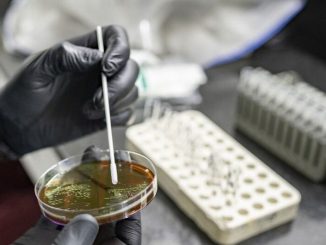

Նոյեմբեր 15, 2025

04 Հուլիս 08:00
Արայիկ Հարությունյանի դիրքերը թուլանո՞ւմ են. երկարատև արձակուրդ է մեկնել. «Ժողովուրդ»
04 Հուլիս 08:00
Արայիկ Հարությունյանի դիրքերը թուլանո՞ւմ են. երկարատև արձակուրդ է մեկնել. «Ժողովուրդ»
 04 Հուլիս 15:07
«Փեթակ» տոնավաճառում հոսանքի լարերից հրդեհ է բռնկվել
04 Հուլիս 15:07
«Փեթակ» տոնավաճառում հոսանքի լարերից հրդեհ է բռնկվել
 04 Հուլիս 18:50
ՏԵՍԱՆՅՈՒԹ․ Արյան հետքերով մեքենա՝ Սպիտակի հիվանդանոցի բակում․ ի՞նչ է պարզվել
04 Հուլիս 18:50
ՏԵՍԱՆՅՈՒԹ․ Արյան հետքերով մեքենա՝ Սպիտակի հիվանդանոցի բակում․ ի՞նչ է պարզվել
 03 Հուլիս 23:10
ՖՈՏՈ․ Ջրհեղեղ՝ Գյումրիում․ ջրի տակ են հայտնվել անգամ քաղաքի պատմական փողոցները
03 Հուլիս 23:10
ՖՈՏՈ․ Ջրհեղեղ՝ Գյումրիում․ ջրի տակ են հայտնվել անգամ քաղաքի պատմական փողոցները
 04 Հուլիս 07:21
Շրջակա միջավայրի նոր նախարարի հայտարարագրերը. ի՞նչ ունեցվածք և եկամուտներ ունի Համբարձում Մաթևոսյանը. «Ժողովուրդ»
04 Հուլիս 07:21
Շրջակա միջավայրի նոր նախարարի հայտարարագրերը. ի՞նչ ունեցվածք և եկամուտներ ունի Համբարձում Մաթևոսյանը. «Ժողովուրդ»
 01 Հուլիս 07:10
Ձուկ մականունով հայտնի Դավիթ Առաքելյանը հեռանում է ԱԺ-ից խոշոր կրիպտոարժույթներով և չգրանցված գույքի օտարմամբ. «Ժողովուրդ»
01 Հուլիս 07:10
Ձուկ մականունով հայտնի Դավիթ Առաքելյանը հեռանում է ԱԺ-ից խոշոր կրիպտոարժույթներով և չգրանցված գույքի օտարմամբ. «Ժողովուրդ»
 30 Հունիս 18:42
Հուլիսի 1-ից ջրամատակարարման գրաֆիկները փոփոխվում են․ մանրամասներ
30 Հունիս 18:42
Հուլիսի 1-ից ջրամատակարարման գրաֆիկները փոփոխվում են․ մանրամասներ
 01 Հուլիս 22:25
Այսօր մենք շատ տհաճ տեղեկություններ ստացանք․ Զելենսկին հետախուզական տվյալներ է ստացել
01 Հուլիս 22:25
Այսօր մենք շատ տհաճ տեղեկություններ ստացանք․ Զելենսկին հետախուզական տվյալներ է ստացել
 01 Հուլիս 18:50
Սուրեն Պապիկյանը պաշտոնից ազատել է «համացանցի հիթ» դարձած վարչության պետին
01 Հուլիս 18:50
Սուրեն Պապիկյանը պաշտոնից ազատել է «համացանցի հիթ» դարձած վարչության պետին
 29 Հունիս 21:00
ՏԵՍԱՆՅՈՒԹ․ Ով էր օգնել Արթուր Ասրյանին՝ «Կուկուին», որ սպաներ Չաղ Ռուստամի հորը․ Սերգեյ Գրիգորյանի՝ «Ֆազի» վրեժը
29 Հունիս 21:00
ՏԵՍԱՆՅՈՒԹ․ Ով էր օգնել Արթուր Ասրյանին՝ «Կուկուին», որ սպաներ Չաղ Ռուստամի հորը․ Սերգեյ Գրիգորյանի՝ «Ֆազի» վրեժը
 15 Հունիս 14:15
ՏԵՍԱՆՅՈՒԹ․ Ովքե՞ր են ՔՊ-ական 64 նոր պատգամավորները․ անուններ
15 Հունիս 14:15
ՏԵՍԱՆՅՈՒԹ․ Ովքե՞ր են ՔՊ-ական 64 նոր պատգամավորները․ անուններ
 07 Հունիս 22:40
Հայտնի են ընտրությունների նախնական արդյունքները` 42 տեղամասից
07 Հունիս 22:40
Հայտնի են ընտրությունների նախնական արդյունքները` 42 տեղամասից
 07 Հունիս 22:26
Որոշ բնակավայրերում հավասար պայքար է․ պատկերն այս պահի դրությամբ (թարմացվող)
07 Հունիս 22:26
Որոշ բնակավայրերում հավասար պայքար է․ պատկերն այս պահի դրությամբ (թարմացվող)
 07 Հունիս 23:38
ՔՊ-ի ձայները նվազեցին․ նախնական տվյալներ
07 Հունիս 23:38
ՔՊ-ի ձայները նվազեցին․ նախնական տվյալներ
 08 Հունիս 11:58
Ովքե՞ր «Ուժեղ Հայաստան» դաշինքից պատգամավորական մանդատ կստանան․ անուններ
08 Հունիս 11:58
Ովքե՞ր «Ուժեղ Հայաստան» դաշինքից պատգամավորական մանդատ կստանան․ անուններ